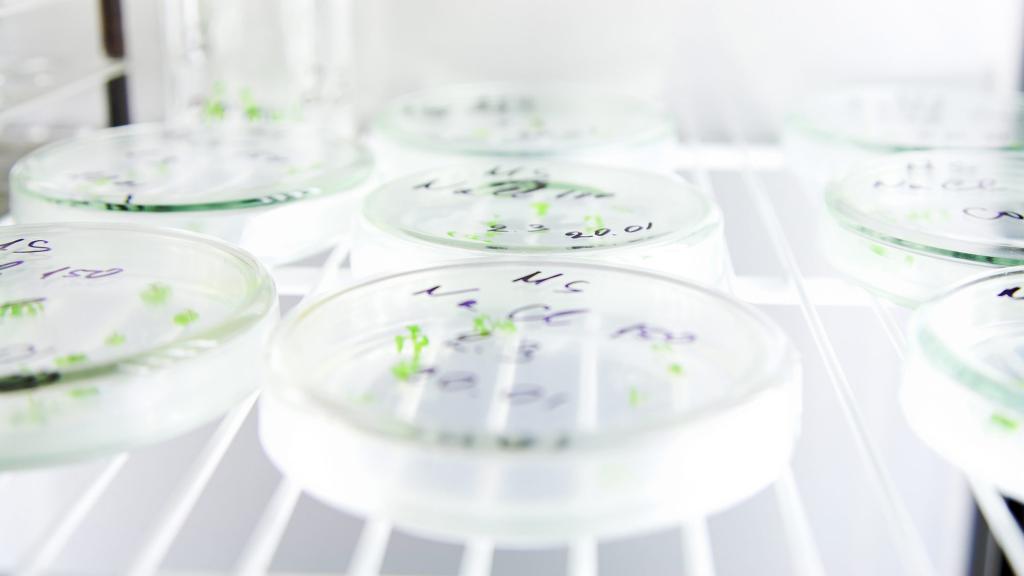

Panic-free GMOs

In This Series
-
Finally, a GMO debate without shouting
Intelligence Squared takes on a contentious issue in a clear way, and the resulting video makes for a great primer on GMOs.
-
OK, GMOs matter — but the noisy fight over them is a distraction
Tom Philpott and Ramez Naam both made sense in their responses to the conclusion of "Panic-free GMOs." Here's what they might have missed.
-
Why GMOs matter — especially for the developing world
Genetically modified food still holds great promise of improving conditions for the world's poor: A second response to our 'Panic-Free GMOs' series.
-
Crop flops: GMOs lead ag down the wrong path
GMO products rarely deliver on the hype, but they've pushed our agricultural system to a critical crossroads -- that's why they matter. First in a series of responses to our coverage.
-
What I learned from six months of GMO research: None of it matters
Why does anyone care about GMOs? Whoever wins the debate, they're not that important to our future. But they're central to the stories we tell.
-
20 GMO questions: Animal, vegetable, controversy?
Here's a bullet-point summation of what Nathanael Johnson learned about GMOs in 2013.
-
Block party: Are activists thwarting GMO innovation?
GM technology hasn't lived up to its hype. Genetic-engineering proponents blame activists. Here's a deeper look at the GMO blame game.
-
Is genetic engineering a doomed effort to reinvent nature’s wheel?
Much GMO research is just walking roads that evolution already tried. Is gene-splicing a dead end and should scientists just move on?
-
Rat retraction reaction: Journal pulls its GMOs-cause-rat-tumors study
Retractions are typically the result of big goofs and frauds -- but in this case, the problem was inordinate attention paid to inconclusive results.